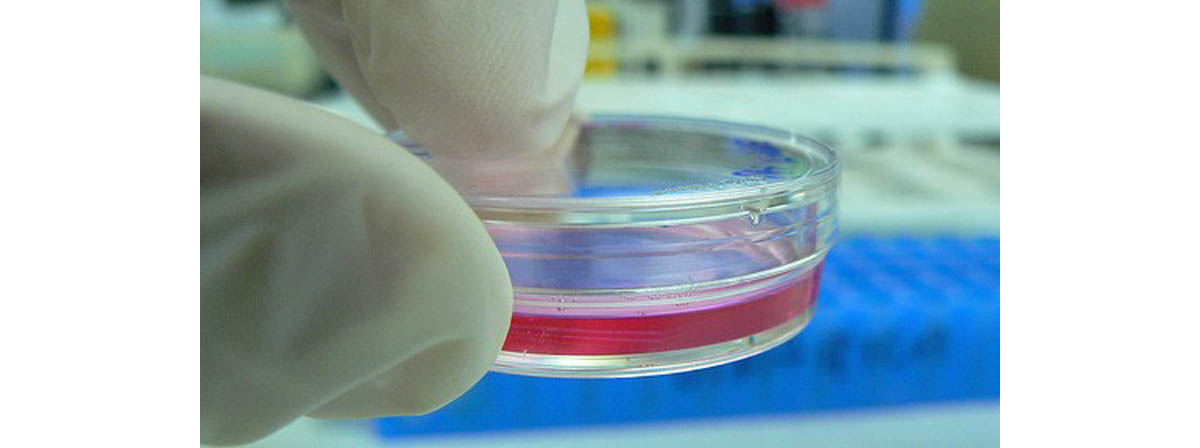

What Is StemSport?
StemSport is a supplement produced by StemTech, a company with its roots in Desert Lake, Oregon, now operating out of California. It consists of the company’s own StemEnhance supplement with some additional substances, and it’s designed to increase the number of adult stem cells circulating through a user’s body.

Stem cells are at the center of a controversy that rages most strongly in the United States where a strong tradition of free enquiry bumps up hard against a powerful and organized religious lobby. That controversy is based on the use of prenatal and umbilical cord stem cells, whose possible uses excite the scientific community and enrage religious people with abortion issues close to their hearts. But the stem cells StemTech are talking about aren’t those stem cells.
Adults continue to produce some stem cells throughout life and a small supply is stored in the brain, which are thought to be part of the explanation behind continued adult neuroplasticity, the process whereby the adult brain changes shape and grows, something it isn’t supposed to be able to do.
The majority of adult stem cells are to be found in the bone marrow.
StemTech explain further: ‘Recent scientific developments have revealed that stem cells derived from the bone marrow, travel throughout the body, and act to support optimal organ and tissue function.’ The rationale behind their product is that: ‘Stem cell enhancers are products that support the natural role of adult stem cells.’
StemSport's Amazing Effects
StemSport is gaining exposure across the web and more and more groups, individuals and organizations are jumping on the bandwagon. The National Basketball Retired Players’ Association featured StemSport in the giftbags the organization gave out at their Phoenix NBA All Star Weekend. On StemSport’s own website, runner Frank Condon says, ‘there are days on the track when I feel as good as I did running for Villanova University – 45 years ago!’
StemSport is especially marketed to the over-50s, with the company’s website claiming that ‘[a]s you age, the number and quality of stem cells that circulate in your body gradually decrease, leaving your body more susceptible to injury and other age-related health challenges.’ In consequence, StemSport is claimed to be able to alleviate problems as diverse as methamphetamine addiction and kidney cysts, in addition to the sport-related recovery improvements the product is actually sold for.
There’s more, though. StemTech’s Chief Science Officer, Christian Drapeau, told The Scientist that he had heard anecdotal support for StemSport including tales of diabetics who had ceased taking insulin, wheelchair users with multiple sclerosis who had begun walking again and Alzheimer’s and Parkinson’s patients who experienced a radical improvement in cognitive function. Mr. Drapeau said, ‘it’s pretty clear it is a natural process of healing,’ and estimated that his company had sold about 50, 000 bottles of StemSport, retailing at $60 each, since November of 2005. ‘Whenever a tissue or organ is in need of assistance, that area of the body will signal adult stem cells via chemical messengers, to release from their primary resting place (the bone marrow), circulate through the bloodstream, and migrate to the organ or tissue in need to help renew it,’ Mr Drapeau explained, and even went on to claim that ‘we are about to submit a study for publication that showed the product helped to renew hair color.’
StemTech Under the Microscope
If all this is beginning to sound a little fishy, that’s appropriate: speaking to NutralIngredients-USA, Ray Carter, CEO of StemTech International, said StemEnhance contained the blue-green algae derivative Aphanizomenon flos-aquae, the herb Polygonum multiflorum, and the fungus Cordyceps sinensis. While Mr. Carter was speaking following a deal to allow StemTech to include Australian biotech firm Marinova’s proprietary Fucoidan ingredient in its next generation StemEnhance product, his list of ingredients have a long history of bold claims –and Mr. Carter and his colleagues have a long history of making them.
As far back as 2002, Gitte S. Jensen, PhD, and Mr. Drapeau published a report in Medical Hypothesis in which they speculated that adult stem cells from bone marrow might be capable of migrating via the circulatory system to tissues around the body where they could effect repair. A few months later, they announced that they had conducted laboratory trials on both humans and animals that showed blue-green algae increased stem cell trafficking, and applied for a patent, which was awarded in November 2004, and in 2005 StemTech Health Sciences, a multilevel marketing company, registered its domain name and began soliciting contributions.
But Mr Drapeau and Dr. Jensen’s involvement with blue-green algae goes back even further than that. In July 2000, they were denied a patent on a blue-green algae product, Summa, which they claimed could be used to ‘maintain a healthy cholesterol level.’ The FDA told them that to make the claim would be illegal.
Later, in 2001, a citizens’ group took CellTech – the company Mr. Drapeau and Dr. Jensen operated before StemTech – to a California court over 30 claims the company had made in their brochures or on their website, and the company lost the case. In February 2003, a judge ruled that all the challenged statements were deceptive and obliged CellTech to repay all the purchase prices to California purchasers of their algae products between 1997 and 2002.
It should come as no surprise that despite StemTech’s many Testimonials and ‘double-blind trials,’ then, many other researchers in the field raise serious doubts that StemEnhance does anything at all.
The Science of StemTech
Mr. Drapeau has claimed that StemEnhance works by blocking L-selectin, a cell adhesion molecule. And while Wotjek Wojakowski, of the Silesian School of Medicine in Katowice, Poland, accepts that in theory a product that acts as an L-Selectin blocker could ‘help with [cells] leaving the marrow,’ he opined that ‘this approach was not tested in clinical studies.’
Furthermore, if cell adhesion sounds to you like something you shouldn’t be playing around with too much, you’re in good company: William Frishman, of the New York Medical College in Valhalla, says, ‘I would look at this with great, great skepticism.’ Thomas Eschenhagen, a professor at the University Medical Center Hamburg-Eppendorf, goes further, warning that while the effects of StemEnhance doesn’t appear to be drastic, based on the information supplied by the company, but whether it’s safe, ‘we simply don’t know,’ and he goes on to state: ‘I strongly advise anybody not to take this drug’ until more studies are done.
What are the dangers StemEnhance could pose? Well, one is the recorded risk of poisoning from ingesting blue-green algae. The Canadian Government warns its citizens of the risks posed by blue-green algae in the wild and observes that they can contain both hepatotoxins, which attack the liver, and nearotoxins, which attack the nervous system.
That doesn’t prove that stemEnhance contains these toxins, however. A secondary danger is the risk that StemEnhance might actually work. If it really releases stem cells form the bone marrow, is that a good thing? Not if you have cancer; some cancers are encouraged to grow faster by the presence of stem cells. Dr. Frischman again: ‘Here [with StemEnhance] you’re giving a general stem cell booster. Some people might have occult malignancies and all of a sudden you’re giving them a stem cell booster.’ Just how effective StemEnhance actually is is open to debate; Mr. Drapeau says he is hesitant to provide too much concrete evidence that it works in case the FDA reclassifies it as a drug requiring a prescription, claiming that ‘We have not yet documented in a rigorous manner the health benefits [of StemEnhance] essentially because they are so obvious, and I am concerned if we get data showing the product is effective...we will be in a difficult position with the FDA.’
One final consideration is the risk to your wallet: One tablet of StemSport costs $1, they’re sold in packages of 60 and the company recommends taking up to 4 daily – netting themselves $120 a month per customer. Wellness Clubs of America founder Dale Peterson comments, ‘People love magic pills, gimmicks & slick web sites, even when they may be hazardous to their health. I have to give StemEnhance's creators credit -- not everyone could turn a potentially deadly pond scum into the cure-for-all-diseases.’
- Photo courtesy of Drew Stephens by Flickr : www.flickr.com/photos/dinomite/6178233760/
- Photo courtesy of Umberto Salvagnin by Flickr : www.flickr.com/photos/34745138@N00/3075268200
- www.nutraingredients-usa.com/Markets/Stemtech-Stem-cell-nutrition-could-eclipse-antioxidant-supplement-market
- www.wired.com/wiredscience/2007/05/supplement_boos/
- www.the-scientist.com/?articles.view/articleNo/25083/title/For-sale--Stem-cell-enhancers/
- www.mlmwatch.org/04C/Stemtech/stemtech.html
- www.optimalwellnessover50.com/stemsport-faq.html
- ejmorris.wordpress.com/2009/02/24/stemsportstem-cell-enhancers-given-to-nba-basketball-legands/
- Foret JB. Letter to Christian Drapeau, July 19, 2000
- www.hc-sc.gc.ca/ewh-semt/pubs/water-eau/cyanobacter-eng.php
- www.stemsport.com/